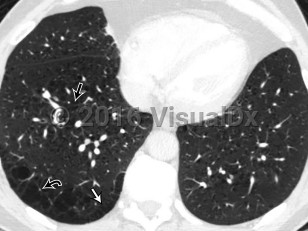

Pulmonary emphysema
Alerts and Notices
Important News & Links
Synopsis

Pulmonary emphysema is a type of chronic obstructive pulmonary disease (COPD) characterized by the loss of individual alveolar wall structures, resulting in larger and less efficient alveoli with air trapping. Shortness of breath begins gradually; it may take years for affected patients to seek treatment. Other findings include wheezing, cough, chest pain, cyanosis, and increased heart rate.
Emphysema is a chronic medical condition. While pharmacologic and lifestyle changes may improve symptoms, in general, patients have a gradual increase in symptoms and burden of disease with time. The primary cause is smoking and/or inhalation of other pollutants. Pulmonary emphysema can also be secondary to alpha-1 antitrypsin deficiency, which leads to unopposed elastase activity in the lung. Treatments include lifestyle changes, supplemental oxygen, medications, and possibly surgery.
Emphysema is a chronic medical condition. While pharmacologic and lifestyle changes may improve symptoms, in general, patients have a gradual increase in symptoms and burden of disease with time. The primary cause is smoking and/or inhalation of other pollutants. Pulmonary emphysema can also be secondary to alpha-1 antitrypsin deficiency, which leads to unopposed elastase activity in the lung. Treatments include lifestyle changes, supplemental oxygen, medications, and possibly surgery.
Codes
ICD10CM:
J43.9 – Emphysema, unspecified
SNOMEDCT:
87433001 – Pulmonary emphysema
J43.9 – Emphysema, unspecified
SNOMEDCT:
87433001 – Pulmonary emphysema
Look For
Subscription Required
Diagnostic Pearls
Subscription Required
Differential Diagnosis & Pitfalls

To perform a comparison, select diagnoses from the classic differential
Subscription Required
Best Tests
Subscription Required
Management Pearls
Subscription Required
Therapy
Subscription Required
References
Subscription Required
Last Reviewed:05/07/2019
Last Updated:05/12/2019
Last Updated:05/12/2019
Pulmonary emphysema